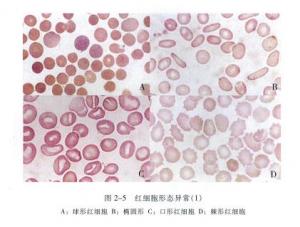

红细胞形态异常一
北京张博士医考检验考试辅导之——红细胞形态异常一
北京张博士医考张银合博士携全体优秀老师助大家考试顺利通过!

【张博士医考www.guojiayikao.com整理,如有转载,请注明出处】
- 免费试听
- 网络课
- 直播课
配套图书
 红宝书/张博士医考红宝书系列2023新版
红宝书/张博士医考红宝书系列2023新版
北京张博士医考检验考试辅导之——红细胞形态异常一
北京张博士医考张银合博士携全体优秀老师助大家考试顺利通过!
【张博士医考www.guojiayikao.com整理,如有转载,请注明出处】
 红宝书/张博士医考红宝书系列2023新版
红宝书/张博士医考红宝书系列2023新版




 京公网安备11010202008671
投诉电话:18701537533 传真:010-63588455
京公网安备11010202008671
投诉电话:18701537533 传真:010-63588455




关注公众号

在线客服